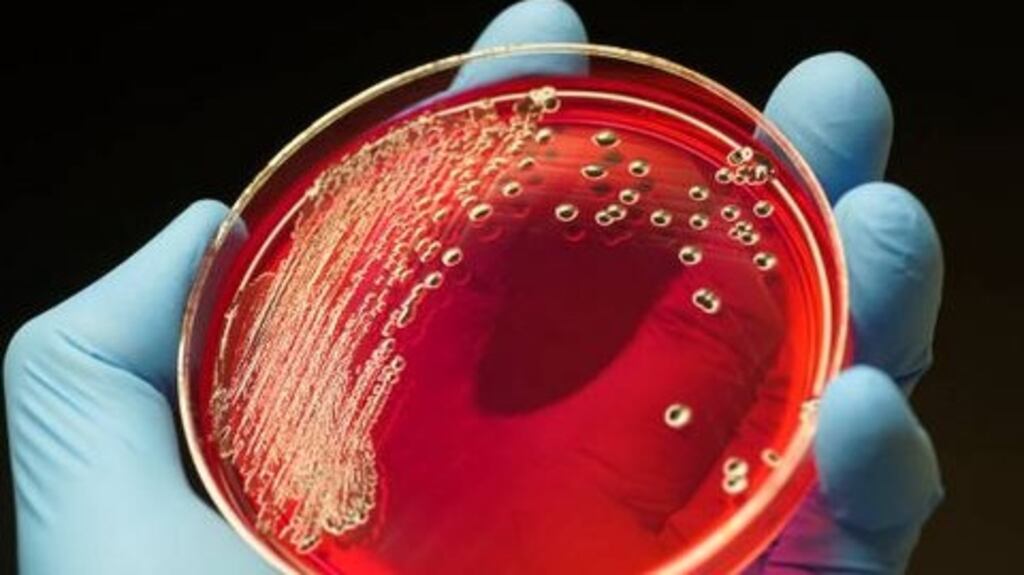
Sepsis is a life-threatening condition triggered when infection in the blood stream overwhelms the body’s immune system. Photograph: ,Getty Images

The number of hospital patients dying from sepsis, the life-threatening condition triggered when infection in the blood stream overwhelms the body’s immune system, has declined, according to the latest statistics.
In 2017, there were 16,312 cases documented among adult patients, with an in-hospital mortality rate of 18.4 per cent – a decrease of 3 per cent on the mortality rate of 2016.
According to the Health Service Executive (HSE), sepsis-associated hospital deaths have fallen by a total of 20 per cent over the past four years in reaction to clinical and preventative measures taken.
"We've come a long way from 2012 and the difficult events there," Minister for Health Simon Harris told the Fifth National Sepsis Summit in Dublin on Tuesday in an apparent reference to Savita Halappanavar.
Ms Halappanavar died from sepsis in October 2012, having been refused an abortion in a Galway hospital while miscarrying. Her case prompted an examination of the effects of the Eighth Amendment and led ultimately to its repealing.
It also prompted a determined assault on the problem of sepsis in hospitals, largely through fostering greater awareness of the condition, leading to earlier diagnosis, and also a heightened emphasis on hygiene.
“The most effective way to reduce mortality from sepsis is by prevention,” the outgoing HSE clinical lead on sepsis, Dr Vida Hamilton, told the conference which was attended by frontline healthcare professionals and other HSE staff.
She said prevention came from “good sanitation, personal hygiene, eating healthily, exercising moderately, breast-feeding, avoiding unnecessary antibiotics and vaccination for vaccine-preventable infections”.
Prof Kevin Rooney of the Scottish national health service and the University of the West of Scotland, told the conference that reducing sepsis had significant beneficial knock-on effects for patients with other conditions. The Scottish NHS had seen a 26 per cent reduction in instances of cardiac arrest because of a reduction in the instances of sepsis.
Patient safety
Thanking all the HSE lead clinicians in the fight against sepsis and front-line nursing staff, Mr Harris said sepsis “can affect any person of any age, irrespective of underlying good health or medical conditions” or social background.
“Sepsis is now a big part of patient safety and a leading cause of death worldwide. If we have learned anything from recent difficulties it has to be about making sure that the patient’s voice is heard.”
He said the report into the instance of sepsis in Irish hospitals, published in parallel with the conference, showed the success that could be achieved from an “evidence-based approach and hard work”.
While the number of documented cases of sepsis in Irish hospitals increased by 16.6 per cent in 2016, the number of deaths decreased by 2.5 per cent, statistical analysis showed. There were 971 cases of septic shock, an increase in 2017 of 5.5 per cent on 2016, with an in-hospital mortality rate of 40.3 per cent, a decrease of 2.7 per cent on the 2016 figure.
The report recommended the development of the sepsis mortality prediction model, continued support for quality improvement efforts to tackle the problem in hospitals, the continued development and improvement of guidelines, awareness-raising and education in primary and community care facilities.